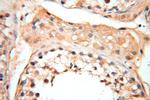
CYP19A1 Antibody in Immunohistochemistry (Paraffin) (IHC (P))

Search
Proteintech
CYP19A1 Polyclonal Antibody
{{$productOrderCtrl.translations['antibody.pdp.commerceCard.promotion.promotions']}}
{{$productOrderCtrl.translations['antibody.pdp.commerceCard.promotion.viewpromo']}}
{{$productOrderCtrl.translations['antibody.pdp.commerceCard.promotion.promocode']}}: {{promo.promoCode}} {{promo.promoTitle}} {{promo.promoDescription}}. {{$productOrderCtrl.translations['antibody.pdp.commerceCard.promotion.learnmore']}}
产品信息
16554-1-AP
种属反应
已发表种属
宿主/亚型
分类
类型
抗原
偶联物
形式
浓度
规格
纯化类型
保存液
内含物
保存条件
运输条件
产品详细信息
Immunogen sequence: MVLEMLNPIH YNITSIVPEA MPAATMPVLL LTGLFLLVWN YEGTSSIPGP GYCMGIGPLI SHGRFLWMGI GSACNYYNRV YGEFMRVWIS GEETLIISKS SSMFHIMKHN HYSSRFGSKL GLQCIGMHEK GIIFNNNPEL WKTTRPFFMK ALSGPGLVRM VTVCAESLKT HLLLFTPASV N
靶标信息
This gene encodes a member of the cytochrome P450 superfamily of enzymes. The cytochrome P450 proteins are monooxygenases which catalyze many reactions involved in drug metabolism and synthesis of cholesterol, steroids and other lipids. This protein localizes to the endoplasmic reticulum and catalyzes the last steps of estrogen biosynthesis, three successive hydroxylations of the A ring of androgens. Mutations in this gene can result in either increased or decreased aromatase activity; the associated phenotypes suggest that estrogen functions both as a sex steroid hormone and in growth or differentiation. The gene expresses two transcript variants.
仅用于科研。不用于诊断过程。未经明确授权不得转售。
生物信息学
蛋白别名: Aromatase; aromatase precursor (EC 1.14.14.1); CYPXIX; cytochrome P-450-Arom; Cytochrome P-450AROM; Cytochrome P450 19A1; cytochrome P450 family 19 subfamily a; Cytochrome P450, 19, aromatase; cytochrome P450, family 19, subfamily A, polypeptide 1; cytochrome P450, subfamily 19; cytochrome P450, subfamily XIX (aromatization of androgens); Estrogen synthase; estrogen synthetase; flavoprotein-linked monooxygenase; MGC104309; microsomal monooxygenase; P-450AROM; unnamed protein product
基因别名: Ar; ArKO; ARO; ARO1; Arom; Aromatase; CPV1; CYAR; CYP19; Cyp19a; CYP19A1; CYPXIX; Int-5; Int5; P-450AROM; p450arom
UniProt ID: (Human) P11511, (Mouse) P28649
Entrez Gene ID: (Human) 1588, (Mouse) 13075, (Rat) 25147